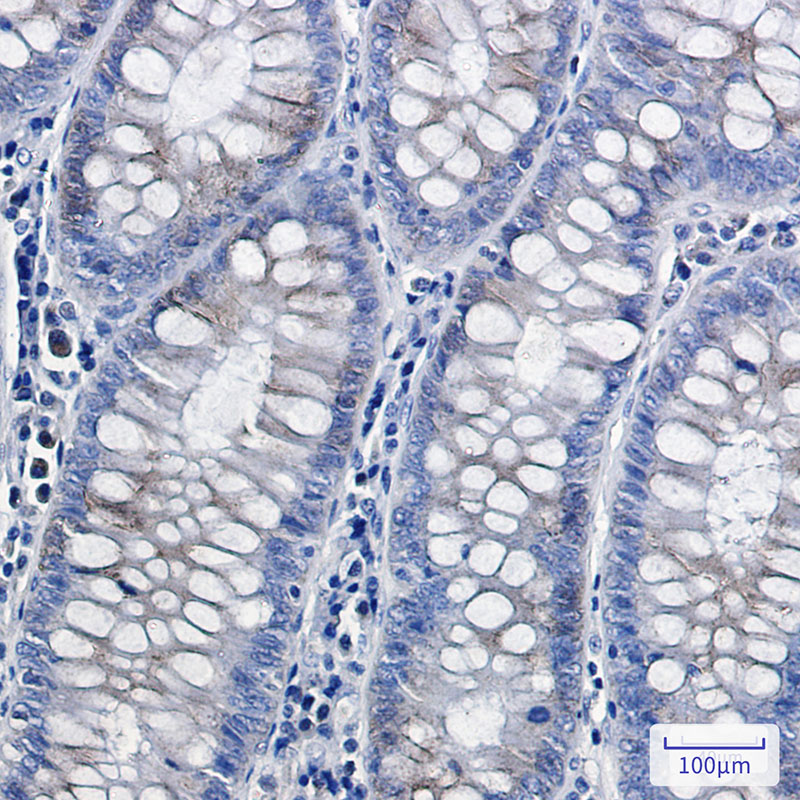

-
分类: 科研抗体货号: P21933别名: RAP1GAP; KIAA0474; RAP1GA1; Rap1 GTPase-activating protein 1; Rap1GAP; Rap1GAP1应用: WB,IP,IF反应种属: Human,Mouse,Rat
-
分类: 科研抗体货号: P21914别名: Ras-related protein Rab-22A应用: WB,IP反应种属: Human,Mouse,Rat
-
分类: 科研抗体货号: P21952别名: PEBP1; PBP; PEBP; Phosphatidylethanolamine-binding protein 1; PEBP-1; HCNPpp; Neuropolypeptide h3; Prostatic-binding protein; Raf kinase inhibitor protein; RKIP应用: WB,IP,IHC反应种属: Human,Mouse,Rat
-
分类: 科研抗体货号: P21932别名: RAP1GAP; KIAA0474; RAP1GA1; Rap1 GTPase-activating protein 1; Rap1GAP; Rap1GAP1应用: WB,IP,IHC,IF反应种属: Human,Mouse,Rat
-
分类: 科研抗体货号: P21943别名: RELB; Transcription factor RelB; I-Rel应用: WB,IP反应种属: Human,Mouse,Rat
-
分类: 科研抗体货号: P21951别名: petC; PGR1; RIP1; RIS1; RISP; UQCR5; UQCRFS1应用: WB,IP,IHC,IF反应种属: Human,Mouse,Rat
-
分类: 科研抗体货号: P21942别名: Receptor expression-enhancing protein 2应用: WB反应种属: Human
-
分类: 科研抗体货号: P21931别名: Ras-related protein Rap-1b; K-REV; RAL1B应用: WB,IP反应种属: Human,Mouse,Rat
-
分类: 科研抗体货号: P21947别名: NR2B1; RXR alpha1; Rxra; RXRalpha1应用: WB,IP,IF反应种属: Human,Rat
-
分类: 科研抗体货号: P21930别名: RAN; ARA24; OK/SW-cl.81; GTP-binding nuclear protein Ran; Androgen receptor-associated protein 24; GTPase Ran; Ras-like protein TC4; Ras-related nuclear protein应用: WB,IP,IF反应种属: Human,Mouse ,Monkey

鄂公网安备42018502007531号
鄂公网安备42018502007531号

